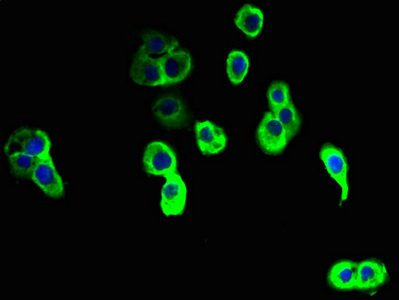

NINJ2 Antibody
-
中文名稱:NINJ2兔多克隆抗體
-
貨號:CSB-PA885775LA01HU
-
規格:¥440
-
圖片:
-
Immunohistochemistry of paraffin-embedded human lung tissue using CSB-PA885775LA01HU at dilution of 1:100
-
Immunohistochemistry of paraffin-embedded human thyroid tissue using CSB-PA885775LA01HU at dilution of 1:100
-
Immunofluorescent analysis of A431 cells using CSB-PA885775LA01HU at dilution of 1:100 and Alexa Fluor 488-congugated AffiniPure Goat Anti-Rabbit IgG(H+L)
-
-
其他:
產品詳情
-
產品名稱:Rabbit anti-Homo sapiens (Human) NINJ2 Polyclonal antibody
-
Uniprot No.:
-
基因名:NINJ2
-
別名:NINJ2; Ninjurin-2; Nerve injury-induced protein 2
-
宿主:Rabbit
-
反應種屬:Human
-
免疫原:Recombinant Human Ninjurin-2 protein (17-81AA)
-
免疫原種屬:Homo sapiens (Human)
-
標記方式:Non-conjugated
本頁面中的產品,NINJ2 Antibody (CSB-PA885775LA01HU),的標記方式是Non-conjugated。對于NINJ2 Antibody,我們還提供其他標記。見下表:
-
克隆類型:Polyclonal
-
抗體亞型:IgG
-
純化方式:>95%, Protein G purified
-
濃度:It differs from different batches. Please contact us to confirm it.
-
保存緩沖液:Preservative: 0.03% Proclin 300
Constituents: 50% Glycerol, 0.01M PBS, PH 7.4 -
產品提供形式:Liquid
-
應用范圍:ELISA, IHC, IF
-
推薦稀釋比:
Application Recommended Dilution IHC 1:20-1:200 IF 1:50-1:200 -
Protocols:
-
儲存條件:Upon receipt, store at -20°C or -80°C. Avoid repeated freeze.
-
貨期:Basically, we can dispatch the products out in 1-3 working days after receiving your orders. Delivery time maybe differs from different purchasing way or location, please kindly consult your local distributors for specific delivery time.
-
用途:For Research Use Only. Not for use in diagnostic or therapeutic procedures.
相關產品
靶點詳情
-
功能:Homophilic cell adhesion molecule that promotes axonal growth. May play a role in nerve regeneration and in the formation and function of other tissues.
-
基因功能參考文獻:
- our study suggests that ninjurin2 is a novel regulator of endothelia inflammation and activation through TLR4 signaling pathways, and these data provided new insights into the mechanisms between NINJ2 and atherosclerosis. PMID: 28431986
- the AA genotype carriers had significantly increased NINJ2 mRNA expression levels in the Chinese population, suggesting that the rs3809263 G > A polymorphism is a functional single nucleotide polymorphism and a biomarker for risk of large artery atherosclerotic stroke. PMID: 26687183
- Data shows that common and rare variants in the NINJ2 region were nominally associated with incident ischemic stroke patients. PMID: 24959832
- Risk of ischemic stroke was higher especially when the carriers of rs11833579 AA NINJ2 genotype were smokers. PMID: 24664524
- Data suggest that the gene NINJ2 rs11833579 A/A or G/A genotype may bring forward the onset age of first-ever ischemic stroke without increasing silent cerebrovascular lesions prior to the stroke. PMID: 22429733
- This meta-analysis suggest that rs12425791 is relative to ischemic stroke risk under dominant model in Asian population, but not for rs11833579. PMID: 22795341
- In this meta-analysis, NINJ2 single-nucleotide polymorphism (SNP) rs12425791 is significantly associated with ischemic stroke in an East Asian (but not Chinese Han) population, of which A alleles increase the risk of ischemic stroke. PMID: 22297388
- A new genetic variant rs10849373 located in the first intron of the NINJ2 gene confers risk of ischemic stroke in Chinese Han subjects. PMID: 21722921
- 12p13 SNPs rs11833579 and rs12425791 within NINJ2 gene do not seem to be associated with ischemic stroke in Chinese Han population PMID: 21376321
- polymorphisms of the vascular susceptibility gene NINJ2 were associated with risk of Alzheimer's disease PMID: 21674003
- There is a significant association between rs11833579 site polymorphism of the NINJ2 gene and risk for stroke in Han Chinese. PMID: 20957003
顯示更多
收起更多
-
亞細胞定位:Membrane; Multi-pass membrane protein.
-
蛋白家族:Ninjurin family
-
組織特異性:Widely expressed. In adult, higher expression in the bone marrow and peripheral blood lymphocytes, medium in the lung, lymph node, thyroid, uterus, thymus, spleen, prostate and skeletal muscle, lower in the liver, placenta, brain, heart and kidney. In emb
-
數據庫鏈接:
Most popular with customers
-
-
YWHAB Recombinant Monoclonal Antibody
Applications: ELISA, WB, IHC, IF, FC
Species Reactivity: Human, Mouse, Rat
-
Phospho-YAP1 (S127) Recombinant Monoclonal Antibody
Applications: ELISA, WB, IHC
Species Reactivity: Human
-
-
-
-
-